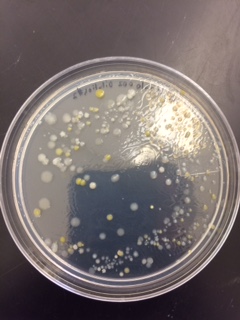
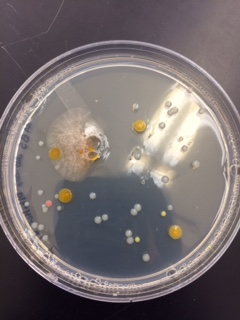

User:Brooke Kazama/Notebook/Biology 210 at AU
February 10, 2016
Excercise V- Invertebrates and Vertebrates
Invertebrate Observations:
| Organism (phylum and class) | Length in mm | Number in Sample | Description of Organism |
| Arthropoda/ Thysanura | 90 | 6 | 6 body segments, 6 legs, body color: brown, 2 antennas, black eyes, tail (?) |
| Arthropoda/ Insecta | 50 | 1 | Clear wings, brown segmented body, no antennas |
| Arthropoda/ Arachnida | 130 | 2 | Greay/ brown body, hairy legs, segmented body, 8 legs, possible black spots |
| Arthropoda/ Insecta | 25 | 1 | yellow, black eyes, antennas, 6 legs, no wings, segmented body, 2 antennas |
| Arthropoda/ Insecta | 20 | 3 | purple-like body color, segmented body, 2 antennas, black eyes |




Conclusion: From the observations stated above, the largest invertebrate present from the Berlese funnel measured 130mm. This invertebrate was of the class arachnida, more commonly known as a spider. The smallest observed invertebrate measured 20mm, which is from the class Insecta. The range of invertebrate sizes was very large from the small sample of leaf litter collected at the transect. The most common invertebrate observed after the Berlese funnel was from the class Thysanura, of which 6 individuals were observed. Of the two samples many more winged invertebrates were observed floating on the ethanol water solution and more spiders were found at the bottom of the collecting container.
Vertebrate Observations (implied):
Eastern Grey Squirrel:Phylum: Chordata Class: Mammalia Order: Rodentia Family: Sicuridae Genus: Sicurus Species: carolinensis
Chipmunk: Phylum: Chordata Class: Mammalia Order: Rodentia Family: Sciuridae Genus: Tamias
Eastern Cottontail: Phylum: Chordata Class: Mammalia Order: Lagomorpha Family: Leporidae Genus: Sylvilagus Species: floridanus
American Robin: Phylum: Chordata Class: Aves Order: Passeriformes Family: Turdidae Genus: Turdus Species: migratorius
Field Sparrow: Phylum: Chordata Class: Aves Order: Passeriformes Family: Emberizidae Genus: Spizella Species: pusilla
Biotic and Abiotic features of Transect: some biotic features of the transect that would benefit species present would include the trees for the birds to hide in, and also to provide food (nuts and seeds). The transect would also provide food for the rabbits, squirrels, and chipmunks. Abiotic features such as the fence would help protect the squirrels and rabbits from larger predators.
Food Web

Description:
February 3, 2016
Exercise IV- Plantae and Fungi
Transect Plant Observations and Characteristics:
Transect Sample Plant #1: Location- Front left bed Description- Green, wide, broad leaf Vascularization- yes Specialized Structures- yes
Transect Sample Plant #2: Location- Back left bed Description- green broad leaf, with white veins present on the underside of the leaf Vascularization- yes Specialized Structure- yes
Transect Sample Plant #3: Location- Front left bed (#2) Description- Long, skinny, narrow leaves, evidence of a flower (dead) Vascularization- no Specialized Structure- yes
Transect Sample Plant #4: Location- Front right bed Description- green, long, narrow leaves, fuzzy stalk, possibility of flowers Vascularization- no Specialized Structure- yes
Transect Sample Plant #5: Location- close to the front entrance of the garden, against the fence Description- broad leaves, jagged, brown, 3 leaves per branch present Vascularization- yes Specialized Structure- yes
Genus of Transect Plants
Transect Plant #1: Aristolochia
Transect Plant #2: Brassica
Transect Plant #3: Silphium
Transect Plant #4: Allium
Transect Plant #5: Rosea
Seeds: Since the transect was observed during the winter, the plants were not producing any flowers at the time. The only indicator of a plant being monocot or dicot rested in the vascular structure of the leaves. Plant #1 was identified as a dicot, Plant #2 is a also a dicot, Plant #3 is identified as a monocot, plant #4 is observed to be a monocot, and plant #5 is a dicot.
Fungi Observations: The sporangia of the fungus is the visible section of the fungus that allows for the spores to be spread to other niches via wind or animals. The sporangia structure is very important because it allows for the haploid spores to interact with other spores creating a different mating type that will then produce more sporangia to then produce spores. There where several different specimens of fungi presented in the lab, but I will focus on the Bread mold fungus. This is a fungus because the structures that protrude from the bread produce spores rather than seeds. This is an indication that bread mold is a fungus. Bread mold is classified as a Zygomycete, because of the fusion of the two different mating type hyphe and the resulting spore forming structure.

BK
January 27, 2016
Exercise III- Microbiology and Identifying Bacteria
Hay Infusion Observation- Murky (muddy) water, suspended sediment, majority of sediment had settled to the bottom of the jar, plant matter had also settled to the bottom of the jar (grasses, leaves, and other plant matter), smelled like sulfur or eggs.
Hypothesis: If the smell and appearance of the hay infusion changes from week to week, then there are various microorganisms breaking down and decomposing the materials within the jar.
Archaea species in agar plates: Archaea are found in environments not unlike the environments millions of years ago. Archaea can be found in the most extreme environments on the planet, including volcanic vents found deep within the ocean, and at extreme freezing temperatures. One obvious reason that Archaea would not have grown on the agar plates is because Archaea could not be found at the transect site. Another reason Archaea could not thrive in agar plates is because the environment is not extreme enough to have the Archaea thrive.
Table 1: 100- fold Serial Dilutions Results
| Dilution | Agar Type | # colonies on Plate | Conversion factor | Colonies/ mL |
| 10^-3 | Nutrient | Lawn | x10^3 | |
| 10^-5 | Nutrient | 200 | x10^5 | 20000000 |
| 10^-7 | Nutrient | 16 | x10^7 | 160000000 |
| 10^-9 | Nutrient | 0 | x10^9 | 0 |
| 10^-3 | Nutrient + Tet | 40 | x10^3 | 40000 |
| 10^-5 | Nutrient + Tet | 4 | x10^5 | 400000 |
| 10^-7 | Nutrient + Tet | 0 | x10^7 | 0 |
| 10^-9 | Nutrient + Tet | 0 | x10^9 | 0 |
Observations:
There is a difference between the nutrient rich versus the nutrient agar with Tetracycline. The nutrient agar proved to be able to grow more bacteria colonies than the agar with tetracycline. This indicates that some of the bacteria and fungi present in the hay infusion did not have the antibiotic resistance to be able to survive within the presence of tetracycline. Tetracycline effected the total number of colonies present on the agar plate, because comparing the nutrient agar with the tetracycline agar, more bacteria colonies were present on the nutrient agar. According to the table above, only about 40 colonies were able to survive.
Effects of Tetracycline:
According to the United States National Library of Medicine, Tetracycline can be used to treat a variety of bacterial infections. These infections include pneumonia, respiratory tract infections, acne, and infections that can cause stomach ulcers. Tetracycline acts to prevent the spread and growth of the bacteria.[1] The types of bacteria that are sensitive to the tetracycline include some gram-positive and gram- negative bacteria. [2]
Observations from negative Tet and positive Tet agar plates:
| Colony | Observation | Motility | Gram Stain |
| Negative Tetracycline | Circular, Convex, undulate, smooth, white | Circular, small, uniform | Negative |
| Negative Tetracycline | Circular, flat, entire (even), yellow | Circular, small, more spread, decreased numbers | Positive |
| Positive Tetracycline | Filamentous, raised, Filamentous, white | Small, bacillus | Negative |
| Positive Tetracycline | Circular, umbonate, entire (even), yellow/ orange | Small, bacillus, coccus, together, uniform, more bacillus shaped than coccus shaped | Negative |
Photos:

BK
January 20, 2016
Exercise II- Identifying Algae and Protists
Hay Infusion- Smell and appearance: Smelled like sulfur (rotten eggs) with earthy (soil-like) undertones. The appearance was brown in color, murky water, floating filament on top, suspended grasses, overall had a uniformly brown color, settled filament on the bottom (looked like spoil, i.e. rocks, small sediment), on the top it looked like there was a white mold growing on top of the sediment. Niches: settled sediment (bottom)- soil, plant matter, pine needles, leaves Suspended (middle)- plant matter, suspended soil floating filament (top)- green plant matter, grass, sludge-like consistency, suspended soil(?)
- Plant matter can prove to have a protective element for some protists, while other protists have the ability to move around. The plant matter can allow for non-motile protists to hang on to a subject and have access to sufficient nutrients.

Identifications
1.) Difflugia- motile amoeba
2.) Chlamydomonas- motile algae, photosynthesizing
3.) Pandorina- motile algae, photosynthesizing
4.) Peranema Sp.- motile protist
5.) Euglena - motile protist, photosynthesizing but also eats other protists
5 Fundamental Characteristics of Life: Energy- The Chlamydomonas is able to produce its own energy through photosynthesis. Cells- The Chlamydomonas is a unicellular algae that is protected by a cell wall. Information- has an (eye) that can detect if the environment has light, but can also survive in total darkness provided acetate is present as an alternative carbon source. Replication- the Chlamydomonas is a haploid cell, in nitrogen deprived conditions two haploid cells of opposite mating types can fuse together (producing a zygospore) for protection. But when conditions stabilize the diploid zygote can undergo meiosis and release the two haploid cells, forming two Chlamydomonas. Evolution- the Chlamydomonas has been able to evolve (Volvox).
- If the hay infusion was to be left for 2 more months, I believe that the smell would be much more prominent, the three different niches would be more distinguishable, the plant matter present, I believe would have changed in appearance (brown, droopy). I also believe that since the hay infusion is within a closed apparatus, each species and colony would feel selective pressures due to space available, food available, and the amount of light reaching the bottle.
Serial Dilution
BK
January 18, 2016
General Characteristics of transect 5: the transect is located on a partial hill, cut in for a community garden. Grassy and open, trees present on the transect's northwest side. Within the American University Community Garden. Wire fence surrounding garden. each garden patch is elevated using wooden planks. Soil found within each patch, three of the five patches contained plants, observed lettuce(?). The floor of the garden consisted of soil and wood chips. Grasses would grow around the peripheral of the transect. Pine needles and other leaves from surrounding trees have settled within the fence of the garden.
Abiotic: metal fence, wood chips, wood planks, nails, dead leaves, wiring (black with rubber surrounding), rubber hose, snow, pine needles
Biotic: plants found within two patches (lettuce?), weeds, grass, small flowering plants, "ground-hugging" plants, dormant rose(?) plants
File:Transect5.pdf


BK









